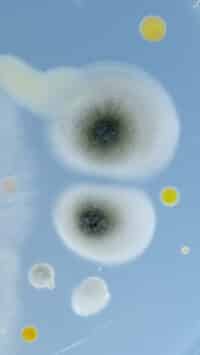

Objectif Chérine. Immersion en terres sauvages
Réalisation :
Manon et Patrick Luneau
Production :
FIFO Distribution
Date de sortie :
2025
Durée :
52 min
Temps fort de cette rencontre avec le réalisateur Patrick Luneau, le film Objectif Chérine dévoile la vie sauvage qui s’épanouit en toute tranquillité dans la Réserve Naturelle de Chérine, au cœur de la Brenne. De nombreuses espèces rares et menacées ont trouvé refuge dans cette immense mosaïque d’étangs et de marais. Au milieu de ces paysages enchanteurs, trois étudiants en cinéma animalier partent en quête du sauvage. Ils n’ont en commun que l’amour de la nature à toutes les échelles ! Ils vivent ainsi leurs premiers affûts et donnent leurs premiers coups de manivelles dans ce monde d’eau et de lumière. À travers leurs regards, même les plus petites bêtes deviennent source d’émerveillement. Leurs pérégrinations et leur apprentissage leur permettront de documenter les richesses de la réserve. Au fil de leurs rencontres, Jeanne, Juliette et Oscar nous entraînent pour une immersion inédite et pleine d’émotions, au cœur de l’un des derniers paradis naturels de France.
Cette soirée sera agrémentée d’échanges autour de ce film et de pépites visuelles proposées par Patrick Luneau : la Cistude d’Europe en hiver, les péripéties d’un Rouge-gorge, le Cincle plongeur et quelques plus grosses bêtes… L’occasion de découvrir son travail !
Voir la bande annonce
En présence de :